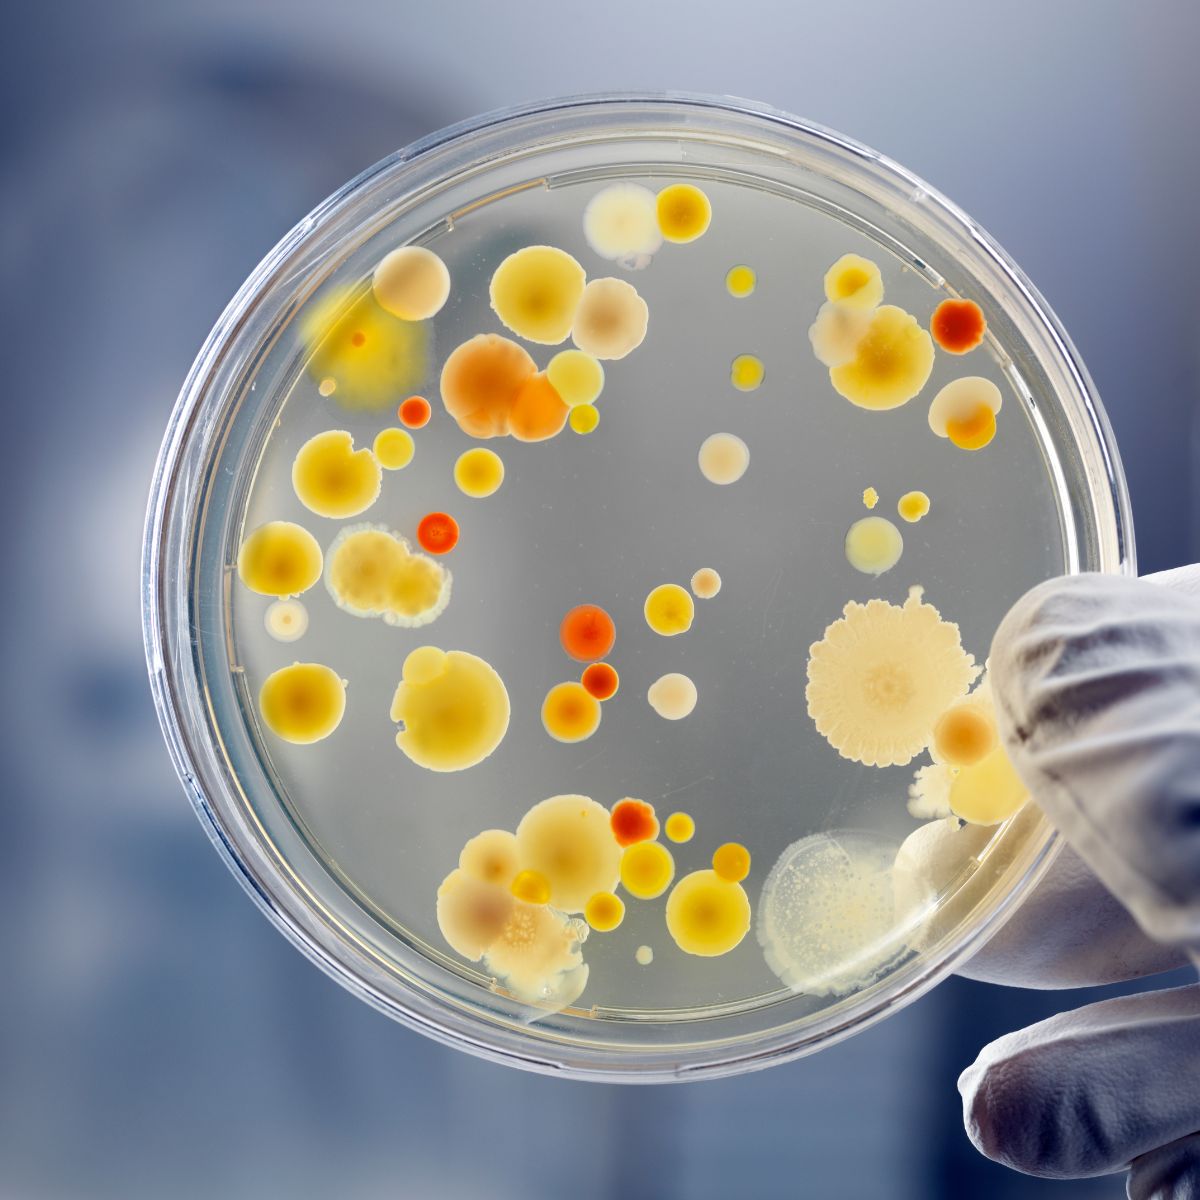

Lees meer over micro-organismen, Inducoat, regelgeving, nieuws en anti-microbiele techniek

Ventileren is essentieel, maar terugkerende schimmel vraagt om een bredere beoordeling
Artikel bekijken
Stille pandemie gaande: zonder ingrijpen groeit aantal ziekenhuisopnamen, overlijdens en ingrepen als amputaties
Artikel bekijken
Zwarte schimmel op het plafond: een zorgvuldige aanpak met ruimte voor de ondergrond
Artikel bekijken
Van vermoeden naar bewijs: hoe een qPCR-schimmeltest leidde tot een gezonder klaslokaal
Artikel bekijken




































